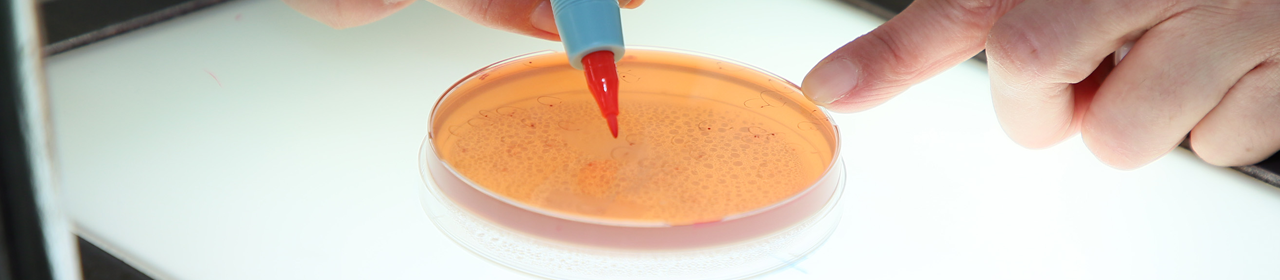

徹底した品質管理で安全で安心できる商品をお届けします。
品質管理への取り組み
原材料
安全な原材料を念頭に使用するヤマイモの原料とともに規定の確認作業と管理を行います。ヤマイモの残留農薬の検査を定期的に実施しています。
工程管理
各工程の抜き取り検査、生産機器の殺菌確認を定期的に行っています。また最新機材による異物混入防止に取り組んでいます。
製品検査
生産ロットごとに微生物・官能検査を行っています。検査員の技能・精度向上のため外部期間での研修を定期的に行っています。
【本社・本社工場・第三工場・帯広工場・営業部】冷凍とろろ芋の設計・開発、製造及び配送、冷凍/冷蔵そうざい(きざみとろろ、和え物、揚げ物、スープ等)の設計・開発、製造及び配送
【石塚工場】乾燥山芋粉末の設計・開発及び製造

